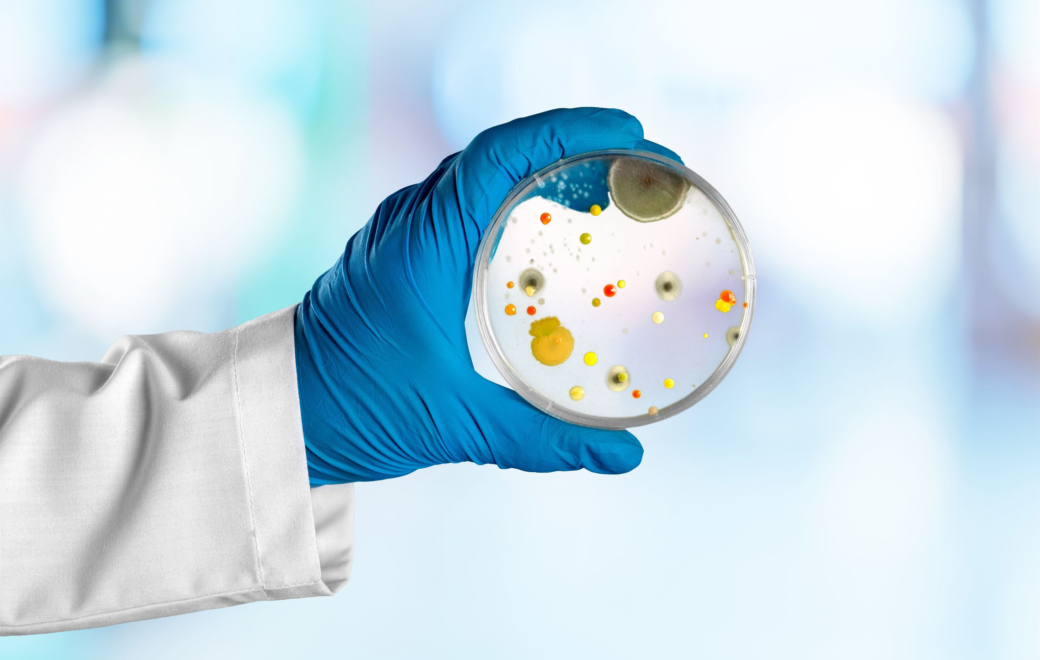
Les probiotiques pourraient-ils aider à limiter les phénomènes d’antibiorésistance ?

- Accueil ›
- Conseils ›
- Santé naturelle ›
- Les probiotiques pourraient-ils aider à limiter les phénomènes d’antibiorésistance ?
© Getty Images
Les probiotiques pourraient-ils aider à limiter les phénomènes d’antibiorésistance ?
Ce n’est pas encore prouvé, néanmoins il s’agit d’une piste intéressante suggérée par des recherches sur le microbiote intestinal et sa capacité à s’opposer à la prolifération de bactéries pathogènes. Ainsi, une équipe de chercheurs de l’université de Rennes (Ille-et-Vilaine) a mis en évidence l’intérêt de Bacteroides fragilis – de la famille des Bacteroidota, particulièrement abondante au niveau du microbiote intestinal – pour limiter la croissance d’une des bactéries pathogènes à l’origine de la salmonellose, Salmonella Heidelberg, cette dernière ayant la particularité de présenter de nombreuses résistances aux antibiotiques. B. fragilis produit des composés bioactifs, parmi lesquels l’acide cholique et l’acide désoxycholique qui, administrés à des souris infectées par S. Heidelberg, réduisent la réaction inflammatoire au niveau intestinal et la capacité du pathogène à passer la barrière intestinale. Ces résultats suggèrent la possibilité de réduire la virulence du pathogène, ce qui pourrait limiter le risque de développement d’une résistance aux antibiotiques. Avec le même objectif, d’autres chercheurs se sont intéressés à Ruminococcus gnavus E1, bactérie symbiotique de l’intestin, qui produit des peptides antimicrobiens, les ruminococcines C. Ces derniers se sont avérés efficaces contre des pathogènes multirésistants aux antibiotiques. Des travaux sont en cours pour identifier les mécanismes d’action et cibles cellulaires de ces peptides.
- Comptoir officinal : optimiser l’espace sans sacrifier la relation patient
- Reishi, shiitaké, maitaké : la poussée des champignons médicinaux
- Budget de la sécu 2026 : quelles mesures concernent les pharmaciens ?
- Cancers féminins : des voies de traitements prometteuses
- Vitamine A Blache 15 000 UI/g : un remplaçant pour Vitamine A Dulcis





